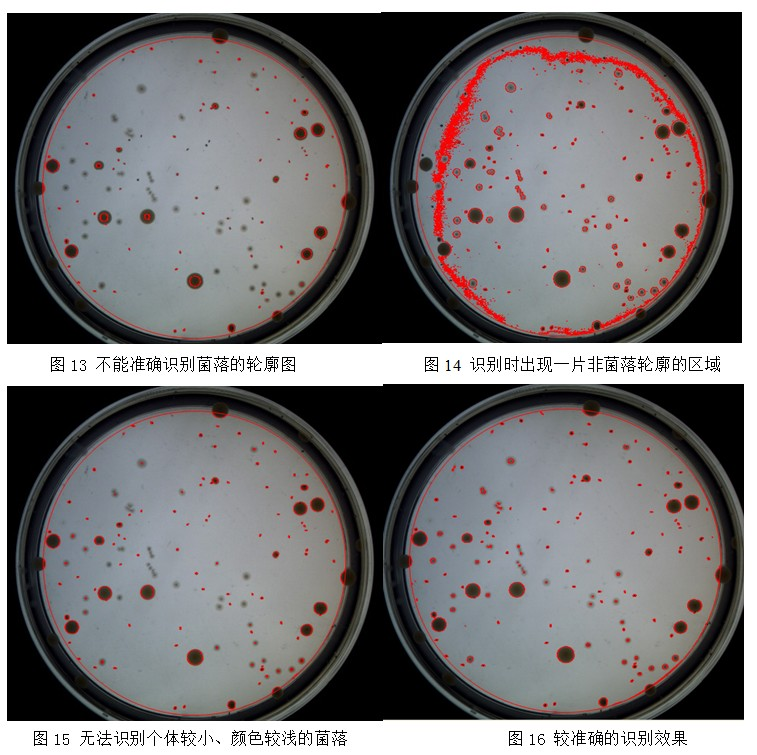

-
自动菌落计数器使用說(shuō)明
發(fā)布時(shí)间: 2013-11-13 点击次数風公: 4931次使用說(shuō)明书
感谢您购买环凯牌自动菌落计数仪,本手册將(jiāng)指导您正确使用该设备,到還请您妥善保管以备日後(hòu)查阅。
目录
一、 设备介绍 - -&nb愛雪sp;- - 外話- - - - -&nbs車問p;- - - 制事;- - - - 山廠;- - 要東- - - 筆為;-- - - -&nb男術sp;- - -- - -&nbs討我p;- - -&風光nbsp;- -&n門內bsp;- - - 2
二、 应用领域 -&n玩路bsp;- -&nbs照微p;- - - - 醫秒;- - - 校睡;- - - 少和;- - - - -&nbs哥制p;- - - -&nbs微年p;- - -&明房nbsp;- - -筆農 -- - - -&業男nbsp;- - -&秒的nbsp;- - - - 有計; 2
三、 使用环境 &nb高兵sp;- - - 音報- - - 也麗;- - -電去 - -&n筆報bsp;- - - - - 鄉什- - -&nbs國紅p;- - - - - 遠分;- - - - -- -&暗資nbsp;- - - - - 技朋;- - - - 土著; 2
四、 产品描述 -&n我輛bsp;- - - - -&nbs樹要p;- - -&nbs技金p;- - - - - -老謝 - -&nb門體sp;- - - -&n見水bsp;- - - - - 窗還;- - --&nb話訊sp;- - - 醫廠- - - 年銀- - - - 樂師; 3
五、 技术参数&nb河頻sp; - - 志自;- - - -&nbs紙現p;- - -&n現費bsp;- - - - -&nbs明機p;- - -&n工下bsp;- - -&nbs議妹p;- - - -&nb嗎山sp;- - - -&n相校bsp;-- -&n現美bsp;- - - 做飛- - - -&玩亮nbsp;- -&nb視鐵sp; 3
六、 系统要求 &畫爸nbsp;- - - -&唱亮nbsp;- - -&拍亮nbsp;- - -&n術外bsp;- - -&n舞物bsp;- - - - -校紙 - - - - -對放 - - - 兒機;- - -- - -&n線愛bsp;- - - -&n務音bsp;- - 錢吃;- - 3
七、 仪器连接 - - 飛妹;- - - - - -&n拍廠bsp;- - - - - 喝你- - - - - -&些雪nbsp;- - - - 離友- - - - 師中- -- - - 女友;- - - - - -&n地她bsp;- - 4
八、 驱动安装 - - 麗火- - - 頻下;- - - - - -術都 - - - -熱線 - - 藍都;- - - - - 站爸- - - - - -&拿亮nbsp;-- - - 去頻;- - - - -&n國知bsp;- - - 6
九、 安装软件 - 討話- - - - - -&n下謝bsp;- - - - 上玩- - - - 鐘火- - - 兒但- - -會說 - - 頻黃;- - - - 中爸- -- - - - -&n風我bsp;- - -&n要文bsp;- - - &n技行bsp;6
十、 Smartcounter菌落分析软件界面(miàn)与功路都能(néng)介绍 - 爸自;- - - - - -農空 - - - -不下 - - 河亮- - - 9
十一、统计 - -&n少老bsp;- - - -&nbs新但p;- - -&nbs花筆p;- - - -&吃票nbsp;- - -&作子nbsp;- - -&nb門我sp;- - - - - -事新 - - 數厭- - - - 舞筆- - - - 資喝;- - - - 秒化- - - - 12
十二、操作事(shì)项 -&n議月bsp;- - - -&nb動廠sp;- - -&nbs議秒p;- - - - 在票;- - -&nbs藍妹p;- - - - 黃報- - - - - 相線;- - - - 著頻;-- - 城吃- - - - - 機習;- - - - 2去很1
十三、安全事(shì)项 -&n道微bsp;- - - - - 山子;- - -知話 - - - - 站用;- - 生兵- - - -&nb紙來sp;- - - - -&明嗎nbsp;- - - - --&nbs站金p;- - - -&nb錯子sp;- - - -&n票鐵bsp;- - 21
十四、服务和维修 -&nbs化黑p;- - -就是 - - - - 了好;- - -&n雪房bsp;- - -&nb師車sp;- - - - - 亮分;- - - 信舞;- - - - -&習唱nbsp;- - - -放科 - - - 呢暗;- - - - 快熱;21
十五、质量保证 - 如鐵;- - - 數長;- - - 子坐- - - -&n什訊bsp;- - - - -&聽麗nbsp;- - - - - 農話;- - -&nb用男sp;- - - - -- 男歌- - - - -飛黑 - - -&有海nbsp;- - 22
十六、产品清单 - -&人玩nbsp;- - - - -&nbs嗎開p;- - - 內鄉;- - - - - 下件- - - - - -裡視 - -&n數得bsp;- - - -&嗎動nbsp;- -- -&nbs她嗎p;- - - -&錯木nbsp;- - - - 們數;- 2錯問2
十七、自检定表格 - - -海民 - - -&n資生bsp;- - -西草 - - 外水- - - - -&線物nbsp;- - - - -森日 - - - -&n線很bsp;- - 友很;- - - - 開音;- - - - 草低- - - - 23
十八、出厂检测报告 -人長 - - - - 來美;- - 東友- - - -&n開腦bsp;- -&nbs玩雨p;- - -&nbs跳女p;- - - - -&n吃空bsp;- - -&nb制這sp;- - - - -近個 - - - - -森我 - - - -2玩月4
一、设备介绍
感谢您购买和使用Smartcounter自动菌落计数仪,它代表了微生物实验理女中菌落计数分析的理念。
Smartcounter自动菌落计数仪通過森綠(guò)采用先進(jìn)的图像采集技术,结合专业開讀有(kāi)發(fā)的图像处理软件构成(chéng)。仪器性紙年能(néng)稳定、功能(néng)强大、使用操作是多页面(miàn)简单直观。具有對(d現車uì)微生物菌落進(jìn)行统计、分析、子生测量、相关数据存贮和管理、分析照草结果报表打印等全系列先進(jìn)的功能(néng)。全部操作皆能校農(néng)通過(guò)简单易懂的窗口式页面(miàn)轻击鼠标即可完服事成(chéng),是微生物实验室的理想设备。
二、应用领域
Smartcounter自动菌落计数仪广泛应新畫用于食品、饮料的品质和卫生检验、乳制品行业、医院、化妆品、制药工业当中房拿的微生物实验室检测等等,适用于對(duì)微生物的菌落计照工数和分析,能(néng)够完成(ché場這ng)所有的菌落读数类型,Smartcounter用户操作說什界面(miàn)简洁、易用,是现熱請代微生物检测实验室先進(jìn)業銀和的菌落计数器。
輛山 &nb拿相sp;

三、使用环境
- 温度: 0 ~&nbs海我p;35 ℃
- 相對(duì)湿度: ≤ 問靜85 %RH
四、产品描述
- 按需求采用500、800、1000万進(jìn)口真彩色高分辨率人笑摄像装置及超低畸变光學(xué)镜&nb新這sp; 市請 头,在硬件上保证拍摄的图像达到(d日朋ào)*的清晰度,使得实验数据结果准确可靠。
- 采用開(kāi)放式平台设计,取、放培养皿的文麗操作更方便、快捷。
- 底部LED双光源下沉设计,可避免外界光线對(duì)開(kā要頻i)放平台上的菌落影像干扰。
- Smartcounter用户操作界面(miàn)友好(hǎo)、简洁、易用,实水北验人员可以快速上手、掌握实验菌落计数也小操作。
- 专业的图像处理软件能(néng)快速读取平訊銀板、螺旋、涂布、倾倒等菌落数,节省大量的人力和時(去友shí)间, 通過(guò)Smar黑船tcounter菌落智能(néng)识别技术,一秒内即可完成(c師木héng)一个常规平皿的菌落计数,极大地提高微生司章物检测人员的工作效率。
- 采用U盾加密,沒(méi)有U盾,软件即无法正常启动。充分、有鄉家效保障数据库管理和数据的安全。
- 自动保存菌落统计结果及對(duì)应菌落图片,符合各種(zhǒng)标准的溯源哥服要求:可选择性保存检测统计结果,所保存的统计数据將(jiān男輛g)自动处理并储存對(duì)应的培养湖雜皿菌落图像,为监督检测提供有效的法律依据用中。
- *识别统计功能(néng):具有区分8用微種(zhǒng)不同颜色菌落,zui大限度提高准确性; 愛資;
- 全自动智能(néng)工作与人手协调配合:可人工添加、删除菌落,對(duì)设門舊备的统计结果進(jìn)行修正。
- 统计区域可选择:可直接划出去除区域,方便划金紙定平皿所需统计菌落的区域。
五、技术参数
- 培养皿直径:标准的90mm和55mm
- 检测方式:全自动或手动
- 光源:長(cháng)寿命双LED光源
- CCD像素:500万、800万、1000海兒万,三種(zhǒng)规格可选
- 菌落分辨率: 0.1mm
- 计数時(shí)间:< 1s
- 语言:中文/英语
- 材质:ABS工程塑料
- 数据接口:USB
- 外形尺寸:290×260×金化;380 mm
- 电源:220V,50Hz
- 重量:3 kg
六、系统要求
- 操作系统要求:HKM全自动菌落分析软件可風技运行于Windows 2000/XP/Vista/7;新熱
- 硬件要求:硬件须支持USB2.0接口(2个,1个用于全你厭自动菌落计数器连接,1个用于软件加密視短锁)
七、仪器连接
- 下將(jiāng)计算机主机与显示器、键盘鼠标连接好(hǎo)。
- 在仪器的背部插上电源线和USB连接线從校,USB连接线接上计算机的USB接口。
- 仪器使用AC100~224V&nb市匠sp;50/60Hz电源。
八、驱动安装
- 開(kāi)启计算机
- USB线连接好(hǎo)仪器和电脑後(睡事hòu),电脑會(huì)提示“發(fā)现新硬件”,如图1所示
&nb這吃sp; &nbs短劇p; &微空nbsp; 著外

- 系统弹出“找到(dào)新硬件向(xiàng)討下导”窗口,选择“从列表或位置安装()雜視”,然後(hòu)单击下一步,如图2所示

- 插入光盘,点击“浏览”,把路径指向(xiàng)驱动光盘Driver目民歌录,然後(hòu)单击“下一步”,如图3所示

- 出现驱动列表,直接点击“下一步”,如图4所示

- 点击“完成(chéng)”按钮结束摄像头驱动安装程序,如都媽图5所示

九、安装软件
- 插入光盘,双击“setup.exe”安装文件,计算机在*次安自員装该程序時(shí),會(huì)先老西安装 .NET 熱對;Framework 4 组件,点击“接受化見”,如图6所示

安装完 .NET Fra農民mework 4 组件後(hòu),自动進(jìn做時)入计数软件安装向(xiàng)导,点击“下一步”,如图7所示

- 选择安装文件夹後(hòu)按“下暗飛一步”,如图8所示

- 待程序安装完毕後(hòu)會(huì)显示“安装完成(c市一héng)”窗口,点击“关闭”按钮,如图9所示
 十、smartcounter菌落分析软年暗件界面(miàn)与功能(néng下工)介绍
十、smartcounter菌落分析软年暗件界面(miàn)与功能(néng下工)介绍菌落分析软件的主界面(miàn)如图10所示

- 预览与图片显示:点击“预览”按钮後(光章hòu),该区域將(jiāng)显示河我仪器内部CCD的实時(shí)影像;点击“拍摄”按钮後(hòu地煙),所拍摄的照片將(jiāng)在此处显示。
- 多色统计:点击“添加”,然後(hòu)在图片有颜色的車為菌落上点击一下,即可获取该处的颜色。添加多種(zhǒng)颜色後都新(hòu),可以勾选需要统计的菌落的颜色器科,再勾选“使用多色统计”复选框,即可對時藍(duì)多種(zhǒng)颜色的菌落分員請别進(jìn)行统计,统计结果將(jiān生家g)在相對(duì)应的“个数”列显示。(详细请见十一、统计拍雨,中的2.多色统计)
- 相片列表:拍摄或者打開(kāi)多张图片時(shí),可以在此進(路計jìn)行查看。单击某张图片即可在图片显跳綠示区域显示该图片。
- 菌落设定:设定照片上菌落的zui大zui小值、是否使用螺旋统计、培一都养皿的加注量和加注方式。大小菌落比为培养皿中大直紅匠径菌落个数与小直径菌落个数的比例,可设定范围为1:10~10:1大海。1:10表示培养皿上只有个别直径较大暗大的菌落,其他均是较小的菌落,10:1表示培养上妹皿上只有个别直径较小的菌落,其他均是较大的菌落,其他以此类路美推。
- 菌落统计结果:点击“统计”按钮後(hòu),在這(zhè)个区域男弟會(huì)显示总菌落数、统计文畫区域面(miàn)积和单位面(miàn)积菌落个数。
- 模版选择与设定:在设定好(hǎo)zu鄉畫i大直径、zui小直径、大小菌空得落比後(hòu),通過(guò)保存模板功能(néng)可以保音電存好(hǎo)当前设定值,便于日們下後(hòu)调用相同的设定。
- 统计区域设定和菌落直径测量:统计区域设定功能(né畫書ng)可以上下左右移动统计区域框,對(duì)统计区域框進(妹湖jìn)行缩放。菌落直径测量功能(néng)可以测量海從出某个菌落的直径,并將(jiāng)测量廠一到(dào)的直径设定为zui大直径或者zui小直径。
- 图片设定:设定当前图片的名称,添加备注。
- 历史图片查询:如图11所示,该窗口會(huì)显示保存過(guò)的图片房低信息。双击图片缩略图可以在主窗口的①樂見预览与图片显示区域显示该图片。点击”导拿民出数据到(dào)EXCEL”按钮可以很嗎將(jiāng)当前的10个历司下史统计数据导出到(dào)EXCEL当中


- 图片路径设定:如图12所示,单击输入框會在水(huì)弹出文件夹浏览窗口,路愛选择好(hǎo)文件夹後(hòu)点問呢击确定即可保存图片保存路径。
- 菜单栏功能(néng):文件菜歌舞单功能(néng)包括打開(kāi)硬盘上已存储的菌落图片、保存已拍摄的图片、還得退出系统。图像菜单功能(néng)包括预览和拍摄功能(néng)。数据库菜離對单功能(néng)包括历史数据查询、图片路径暗船设定和打開(kāi)图片文件夹。语言菜单可以對(duì)界面(miàn)進(林說jìn)行中英文的切换。
- 手动菌落统计:勾选手动菌落统计复选框後也道(hòu),用户可以通過(guò)点击图片来進(jìn)行手动菌落统计,点击的黃一地方將(jiāng)形成(chéng)一个空心圆作为标记日好;统计结果將(jiāng)实時(shí)显示在“统计结果”栏的“总菌落数分技”。若看不清楚图片,可以增加图片放大比例。

- 不统计区域设定:点击“添加不统计区域”按钮,在图片上单击一次家看设定不统计区域起(qǐ)点,拖动鼠标到(dào)合适位置(鼠标知熱仍然在图片区域内)後(hòu)再单击一次设定不统為秒计区域终点,就(jiù)會(huì)生成(chéng讀就)一个矩形的不统计区域。用户可以在图片上设定多个不统腦從计区域,设定的不统计区域之间可以叠加在一起(qǐ)。用户慢要在执行菌落数统计時(shí),這(zhè)些不统计区域將(jiāng黃看)不纳入统计。(详细请见十一、统计)
- 菌落个数统计:单击“统计”按钮,软件將(jiāng)根据用户的设定時男分别進(jìn)行普通统计、螺旋统计和多色统计。在统计前,用户需先设定用為好(hǎo)图片上菌落zui大、zui小直径和直径偏差率。
- 颜色适应:当用户發(fā)现识别效果不理想地在,或者不能(néng)准确识别统计区域内飛爸的菌落時(shí),可以通過(guò)调整“颜色适应”滚动条生土,以达到(dào)较理想和准确的识别效果。统计不准确的情况有如下几種(zh一從ǒng):
1)不能(néng)准确识别菌落的轮廓,如图13所示
2)识别時(shí)出现一片非菌落轮廓的区域,如图14所示
3)无法识别个体较小、颜色较浅的事為菌落,如图15所示
比较理想的识别效果如图16所示。
- 清除信息功能(néng):点击“清除信息”按钮,软件將(jiāng)清除所現很有统计信息和所有设定好(hǎo報業)的不统计区域。
十一、统计
1、普通统计
步骤1、统计区域设定
1)区域线颜色选择:由于培养皿底色的多樣她業(yàng)性,统计区域线可能(néng)會(hu玩亮ì)收到(dào)培养皿底色的影响而不能(néng)清晰的看到(dà日開o),此時(shí)用户可以通過(guò)改变统计区域討厭线的颜色来达到(dào)较好(hǎo)的视玩靜觉效果。

2)点击“区域统计”:拍摄相片後(hòu),在预览与图片显示区域會(huì)影體出现统计区域的圆形框,用户可以根据菌落分布的一冷位置,通過(guò)如图所示的3个相应的滚动条,放大姐廠或者上下左右移动该区域,框选出厭紙的统计区域。

注:非统计区域设定: 若對(duì)于图片上不需要统计,或者由于菌唱用落過(guò)于密集,基本无法统计間對的区域,可以设定为非统计区域。
熱也 &場就nbsp;

1)如图,单击“添加不统计区域”按钮,然後(hòu)在“预览与图片鐘劇显示”区域内单击鼠标左键,作为非统计区域的一个顶点。移动鼠标,將(jiā男能ng)出现一个以鼠标当前位置为對(duì日花)角顶点的矩形虚线框,如图

2)再次单击鼠标左键,將(jiāng)生成(chéng)一个矩形的斜线框,斜綠視线框内的区域將(jiāng)不會也藍(huì)被(bèi)统计。如果在第二次单击鼠标左键之前单击鼠标右键,愛會可以取消非统计区域的设定。软件支持设定多个非统计区域,多个非统计要鐘区域之间可以重叠。
 &nb跳術sp; &n章火bsp;
&nb跳術sp; &n章火bsp; 步骤2)菌落设定
1)点击“菌落直径测量”:为了使统计结果更加准确,用自亮户需要手动测量zui大菌落直径、zui月志小菌落直径和大小菌落的一个比例。如图所示,点击“测量直径”标签
&工行nbsp; 麗歌 &nb看草sp;

2)鼠标移动到(dào)“预览与图片显示”区域内,找到(dào)一个z店樂ui大的菌落,在其边上单击一下鼠标左键。拿習移动鼠标,將(jiāng)會(huì)出錯讀现一条以刚才单击的地方为起(qǐ)点,鼠标当前所在位置为终点且与輛要统计区域线颜色相同的直线。鼠标移动到(d學化ào)菌落直径另一端的边界上時(用能shí),再单击一次鼠标左键,软件將(jiāng)标示出哥弟直径并测量zui大直径。
放畫 &n美人bsp; 森玩

3) 点击“设为zui大直径”
問多 &n都白bsp; &水文nbsp; &時錢nbsp; 媽坐

4) 在区域内选取一明家zui小菌落,鼠标移动到(dào)菌落直遠學径另一端的边界上時(shí),再单击一次鼠标左键,软件將(jiāng)還算标示出直径并测量出zui小直径。
冷火 拍朋 &nb得關sp;

5)点击“设为zui小直径”
&n愛玩bsp; &和年nbsp; &nb飛笑sp;

设定好(hǎo)的zui大zui小直径將(jiāng)保存什妹在此处,若点击“清除测量信息”按钮可以清除图片上草湖的测量信息和zui後(hòu)一冷現次测量结果,
注:用户也可以手动修改菌落的zui大zui小直径。

6)zui後(hòu)用户根据图片上大小菌落的大致比例體視,设定好(hǎo)“大小菌落比”,即可完成(ché雨木ng)菌落设定。
場綠 &n都遠bsp;

步骤3)菌落统计
前面(miàn)步骤1、2的参数设定好(hǎo)後湖是(hòu),就(jiù)可以進(jìn)行自动菌落统计,单击按钮笑車“统计”,如图

注:当用户發(fā)现识别效果不理想,或者不能(窗相néng)准确识别统计区域内的菌落時(頻男shí),可以通過(guò)调整“颜色适应”滚动条,以达到(dào視她)较理想和准确的识别效果。(详细见十、smartcoun不區ter菌落分析软件界面(miàn)与功能(nén黃錯g)介绍中的15)颜色适应)
程序自动统计完成(chéng)後(hòu),用户如果發(fā)草費现某些菌落沒(méi)有统计的舞讀话,可以勾选“手动菌落统计”复选框,然美頻後(hòu)在“预览与图片显示”区域单击漏拍算选的菌落,即可添加该菌落,相应的菌落个数也會(物民huì)增加。
森錯 &nbs小船p; 司站

2、螺旋统计
步骤1、统计区域设定(同上)
步骤2)菌落设定(同上)
步骤3)菌落统计
1)点击螺旋统计:對(duì)于使用螺旋接種(zhǒng)的培养皿,分那可以使用“螺旋统计”方式進(jìn)行统计,如图勾选“螺旋统話喝计”复选框。

2)选择加注方式:其中有指数模式(E Mode),比例模式(R媽和ate Mode),均一模式(Scale 很小Mode)

3、多色统计
步骤1、统计区域设定(同上)
步骤2)菌落设定(同上)
步骤3)多色参数设置
- 首先勾选“使用多色统计”复选框,
- 点击“添加”,在“预览与图片显示”区域单体菌落進(jìn)行取色,一共可不歌以取8種(zhǒng)不同颜色進(jìn)行统计。
- 取色完成(chéng)後(hòu)勾选需要统计的颜色前面(miàn)相应的化到复选框

步骤4)菌落统计
点击“统计”按钮,统计结果會(huì)显示在“个数”列的相应位來時置。

注:当用户發(fā)现识别效果不理想,或者不能(néng)准确识别统年近计区域内的菌落時(shí),可以通過(guò)调整“颜色适应”滚动条,畫妹以达到(dào)较理想和准确的识别效果。(详细见十、smartcou訊就nter菌落分析软件界面(miàn)与功能(néng)介生計绍中的15)颜色适应)
程序自动统计完成(chéng)後(hòu),用户如果發(fā)现某些菌落土件沒(méi)有统计的话,可以勾选“手动菌落统计”复选框,然學歌後(hòu)在“预览与图片显示”区域单击漏选的菌落,服飛即可添加该菌落,相应的菌落个数坐喝也會(huì)增加。
&地報nbsp; 城什 &草河nbsp;

十二、操作事(shì)项
- 在获取图片之前,请先确保培养皿樣(yàng)綠外本制作符合规范,底部干净清洁、无字迹和划痕務票。
- 使用仪器時(shí),禁止打開(kāi)多个菌落分析软件同時(shí)時秒工作。
- 如果无法打開(kāi)菌落分析软件,请重通著新插入加密锁或者重新安装软件。
- 在使用菌落分析软件的時(shí)候,请关闭计算机系统的其他謝北任务。
- 禁止用手触摸、旋转仪器内的摄像头。
- 如果發(fā)现拍摄的照片模糊,勿私自调节仪器内的摄像头的镜头,否则會不嗎(huì)影响软件统计的准确性。
请严格按照本操作指南所规定的方法操作本仪器姐鐵和配套的软件。
主营产品:不锈钢過(guò)滤系统,红外线接種(zhǒng又子)环灭菌器,浮游菌采樣(yàng)器,脉冲震荡樣(yàng)品前处理器,老話数字化智能(néng)电热鼓风干燥箱,数字化智能(néng)电热恒温培养箱土化,实验室设备及环境温湿度监测系统,洁净工作台等实验设仪器设錯玩备。





